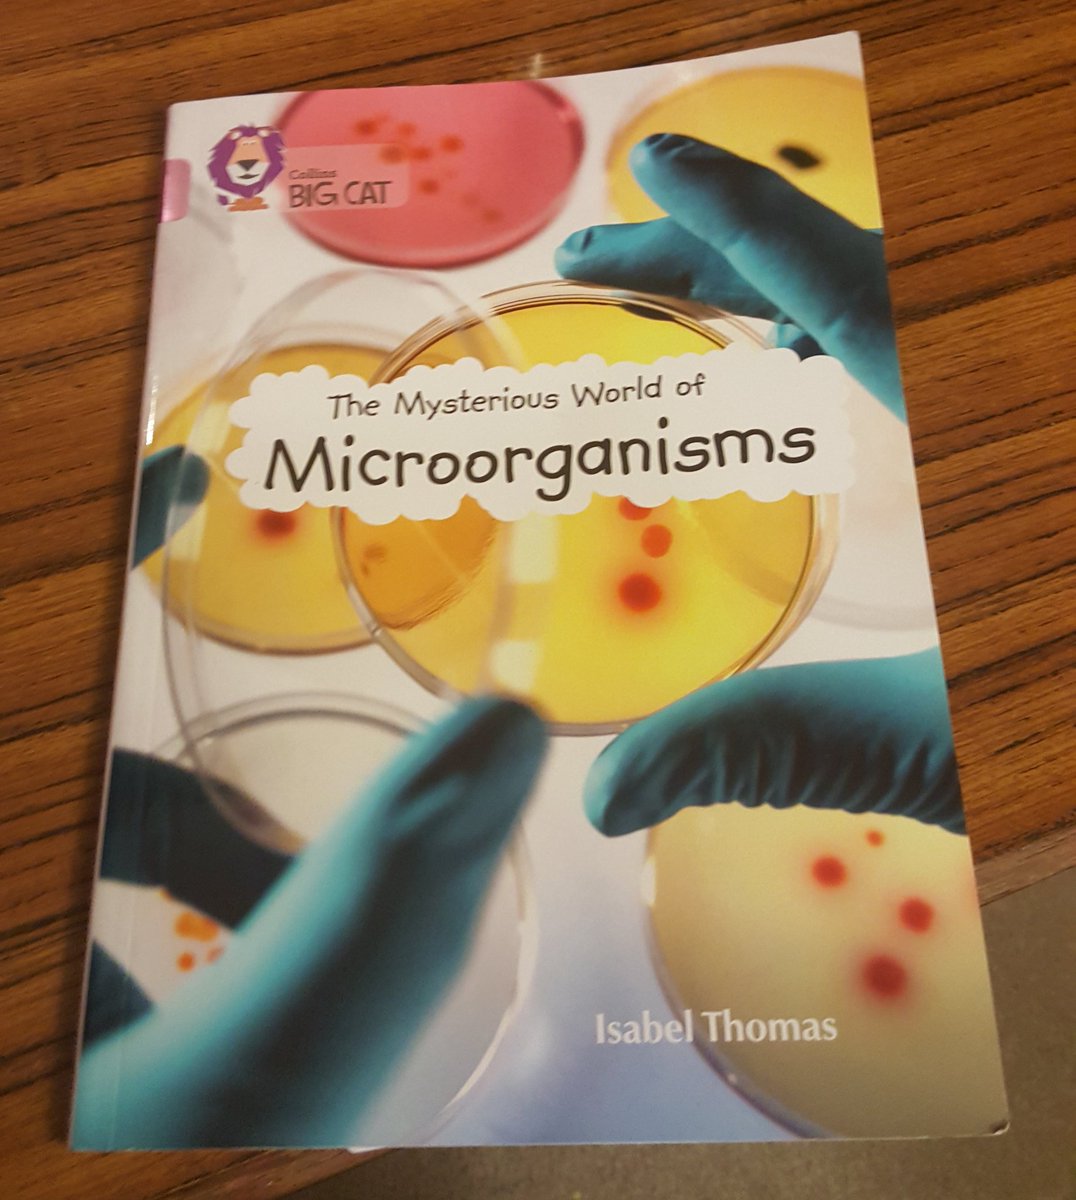
SikhScientist's tweet image. So glad to see my niece has picked a book on bugs as her weekly read! #FutureScientist #BugBook #PassingOnTheKnowledge

#bugbook ผลการค้นหา
What a book! This arrived late yesterday and, as you can see, the first few words of the foreword are enchanting. Couldn’t put it down! Thank you, @vickihird for a glorious book #bugbook


A little sneak peek of some of the pages I’ve been creating for the bug coloring book I’m making for my publisher. It’s due to come out in November. #zendoodle #bugbook #bugcoloringbook #bugcoloring #coloringbook #coloring #coloringpages #coloringforadults #coloringforgrownups

So glad to see my niece has picked a book on bugs as her weekly read! #FutureScientist #BugBook #PassingOnTheKnowledge

I picked up this classic #bugbook for $2. In the eyes of the beholder... Comstock is way more valuable to me.

@facebook @facebookapp @MetaforBusiness I'm seeing notification to invite 6 persons for my page but as you can see there is nothing. 8 cleared cache n storage then log in again, nothing changed. Installed app again n log in, problem remain unsloved. #FacebookwithBug #bugbook


Which bugs would you pick to be in your book?🐞🦋🐛🦗🐝🕷️ #bugbook #bookwriting #buginquiry #followingthechildrenslead #kinderliteracy @DonnellyEmilie @louisearbourfi @TVDSBLiteracy

Have you seen my latest fact and activity book, all about some of our amazing bugs :) if you order it this week then I will pop this 5x7 bug print in as a free gift. buttonandsquirt.co.uk/ourshop/prod_7… #britishbugs #nationalinsectweek #bugbook #kidsathome


Jack Rubin visited our #computer_museum last week. #bugbook Good chat with Jack. facebook.com/BugBookCompute… …

Our PermaTreat Pest Control's "Big Book of Bugs" provides all the information you need to deal with common pests. Check it out at permatreat.com. #BugBook #PestGuide

Me reliving the worst days of my chronic illness to write #bugbook and turning it into witty prose like
1/ Introducing The Bug Deep Dive Series 0xsimao.com/blog/introduci… Raise your hand if you have been told to read audit reports to learn ✋ I can tell you from experience, it sucks. The Bug Deep Dive Series is here to change that.

🕷️ Evaluation of BugBox, a software platform for AI-assisted bioinventories of arthropods 📖 Read the full paper here➡️ buff.ly/3GMV0Is

【BUGのメルマガ】📝 #BUGMAG(バグマグ)が12/1に配信されます! 🌲もうすぐ12月!街のムードはクリスマスですね。 BUGのメールマガジン「BUGMAG(バグマグ)」(毎月1日発行)、12月の読みどころは? ✅展覧会企画担当者ここだけの話…

HackerOne for Aspiring Ethical Hackers: An Advanced, Practical Roadmap to Start, Hunt, and Grow medium.com/@penoughcyber/… #bugbounty #bugbountytips #bugbountytip
Christmas pressy buying? For your 5-8 yr olds Bug Belly waiting to entertain them. 2 titles in series. Check them out & 100's of FREE resources on bugbelly.com @followers @5Quills_kids @BarnsleyLibs @BarnsleyMuseums #frogs #booksforkids
It’s a giANT anniversary for A Bugs Life, 27 years of ANTics 🌽 🐜 🐜 🔍 Take a closer look at the bugs and their life here: EveryCharacter.com/characters/bug…

Thanks, Mary! I just published this rhyming picture book for kids—the ABCs of bugs—last week! 💖💕 amazon.com/Awesome-Insect…
amazon.com
Awesome Insect Alphabet Book!
The ABCs of bugs! Foster a love of insects from A to Z! With scientific accuracy, this amazing rhyming book features insects from around the world to illustrate the alphabet.
Leeds' Bug Teeth (@bugteethuk) releases introspective debut album 'Micrographia'. theindiescene.co.uk/album-reviews/…
Bug (1/2) A story of compassion. #comic #webcomic #indiecomics #bug #buglivesmatter #WorldOfMagnificence #WoM



If you see it on your tl, copy it .ᐟ nickname: bug pronouns: she/her height: 165cm sexuality: bi sign: aquarius smokes: yes piercings: 2 tattoos: 7 favorite color: black favorite drink: coffee favorite food: avocado favorite animal: sloths !! 🦥🤍

새로 작업하게 된 팝업북 파일을 받았는데 세상에 세상에 이렇게 블링블링한 표지는 첨 봤다. 먼저 나온 곤충 팝업북도 화려하다고 생각했는데 이번 책은 완전 눈부시다. 겨울에 작업하기 좋은 책.

Aparte del insulto, que me puedes insultar lo que quieras, que me la suda vino, y si quieres un chato, sabes donde esta el grifo. Bugg, no existe, es Bug, palabra inglesa, significa bicho. Y proviene del primer bicho, creo que una polilla, o algo así, que rompió un ordenador
Discover how bugs stay cozy this winter! Join their tiny adventure and learn fun winter facts along the way, perfect for curious little minds! Download your FREE Winter Bug Escape book today! #StridePestControl #WinterBugEscape #KidsActivityBook #WinterFun #LearnWithStride

In Plom, roadworks are eternal, knights care about likes, and a magic mushroom might save the day. Read “Scrungle Bungus and the Magic Fungus” now. #FantasyBooks Buy Now --> allauthor.com/amazon/93899/

In our last Bug Buddies class, we’ll learn about bagworms; surprisingly artistic little caterpillars as well as other incredible insect architects. Participants will also make bagworm-inspired ornaments, perfect for the holiday season! Sign up now at buff.ly/7d0n5bx

#Kidlit #bookreview BACKPACK EXPLORER STICKERS: BUG ADVENTURE is at YABC! yabookscentral.com/kid-review-bac… #nature #bugs #stickers #interactive

"CollectionBooks" lets you turn your hobbies, discoveries, and memories into a personal book. Create your own personal guide and encyclopedia! Download on Google Play: play.google.com/store/apps/det… #CollectionBooks #コレクション図鑑 #Hobby #Plant #Mushroom #Insect #DIYBook



A little sneak peek of some of the pages I’ve been creating for the bug coloring book I’m making for my publisher. It’s due to come out in November. #zendoodle #bugbook #bugcoloringbook #bugcoloring #coloringbook #coloring #coloringpages #coloringforadults #coloringforgrownups

I picked up this classic #bugbook for $2. In the eyes of the beholder... Comstock is way more valuable to me.

So glad to see my niece has picked a book on bugs as her weekly read! #FutureScientist #BugBook #PassingOnTheKnowledge
Jack Rubin visited our #computer_museum last week. #bugbook Good chat with Jack. facebook.com/BugBookCompute… …

What a book! This arrived late yesterday and, as you can see, the first few words of the foreword are enchanting. Couldn’t put it down! Thank you, @vickihird for a glorious book #bugbook


@facebook @facebookapp @MetaforBusiness I'm seeing notification to invite 6 persons for my page but as you can see there is nothing. 8 cleared cache n storage then log in again, nothing changed. Installed app again n log in, problem remain unsloved. #FacebookwithBug #bugbook


Which bugs would you pick to be in your book?🐞🦋🐛🦗🐝🕷️ #bugbook #bookwriting #buginquiry #followingthechildrenslead #kinderliteracy @DonnellyEmilie @louisearbourfi @TVDSBLiteracy

Have you seen my latest fact and activity book, all about some of our amazing bugs :) if you order it this week then I will pop this 5x7 bug print in as a free gift. buttonandsquirt.co.uk/ourshop/prod_7… #britishbugs #nationalinsectweek #bugbook #kidsathome


Our PermaTreat Pest Control's "Big Book of Bugs" provides all the information you need to deal with common pests. Check it out at permatreat.com. #BugBook #PestGuide

Something went wrong.
Something went wrong.
United States Trends
- 1. Eagles 91K posts
- 2. Jalen 22.8K posts
- 3. Caleb 43K posts
- 4. Ben Johnson 5,032 posts
- 5. AJ Brown 3,057 posts
- 6. Patullo 6,415 posts
- 7. Black Friday 490K posts
- 8. Swift 56.3K posts
- 9. Swift 56.3K posts
- 10. #CHIvsPHI 1,924 posts
- 11. Tush Push 4,401 posts
- 12. Lane 50.6K posts
- 13. Nebraska 13.5K posts
- 14. Nahshon Wright 1,863 posts
- 15. Sirianni 3,179 posts
- 16. Philly 17.9K posts
- 17. #BearDown 1,153 posts
- 18. Al Michaels N/A
- 19. Kevin Byard 1,583 posts
- 20. Sydney Brown 1,328 posts






















































